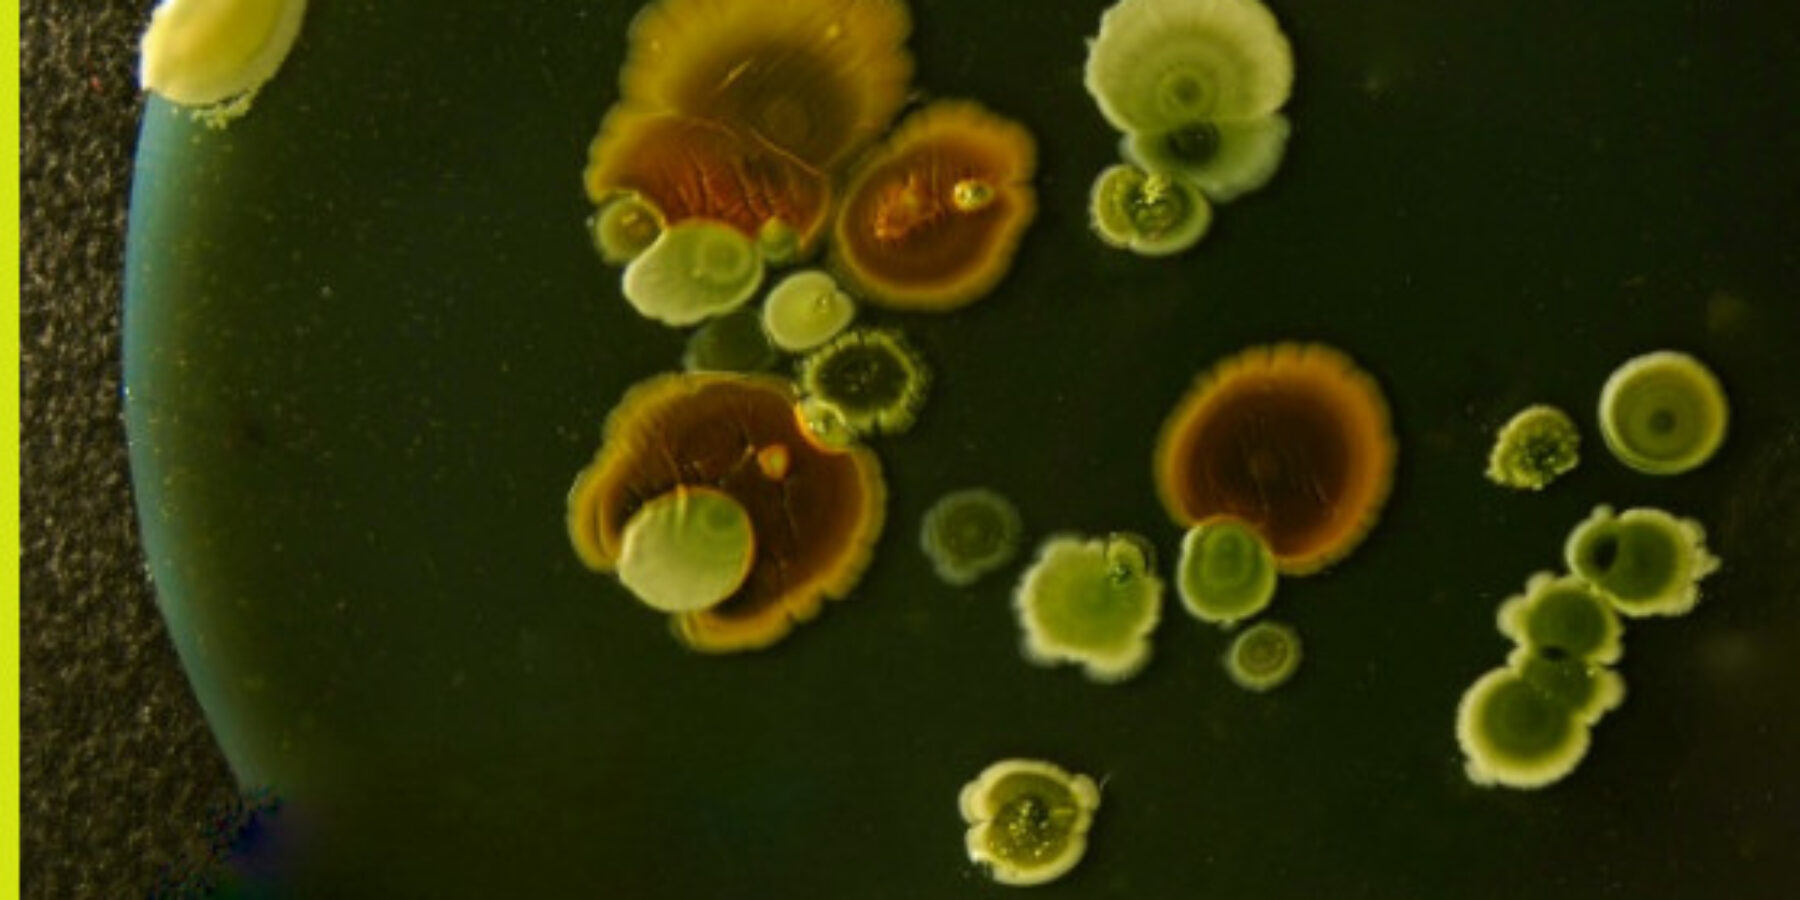

Hermelijn Smits, immunoloog aan het LUMC en expert op het gebied van omgevingsinvloeden op het immuunsysteem, geeft bij Sciencecafé Leiden een lezing over de zogenaamde old friends-hypothese: het idee dat ons immuunsysteem zich gedurende de evolutie heeft ontwikkeld in nauwe samenwerking met bepaalde micro-organismen, die het helpen om tolerant en in balans te blijven. Ook komt de Finse biodiversity hypothesis aan bod. Die stelt dat een rijke biodiversiteit in onze leefomgeving samenhangt met een gezonder microbioom en minder allergieën.
Ons immuunsysteem ontwikkelt zich in voortdurende wisselwerking met de wereld om ons heen. Niet zozeer meer hygiëne, maar vooral een veranderde leefomgeving lijkt een belangrijke rol te spelen in de toename van allergieën en andere immuniteit-gerelateerde aandoeningen. Kinderen die opgroeien in een stedelijke omgeving komen in contact met een andere, vaak minder diverse verzameling micro-organismen dan kinderen op het platteland, waar dieren, bodem en planten een rijk microbieel landschap vormen.
Traditioneel wordt de avond omlijst met livemuziek. Deze avond door rock ’n roll singer-songwriter Beechcraft Bonanza (Guido Kreeuseler) uit Almere met zelfgeschreven nummers en covers geïnspireerd op jaren ’50 rockabilly, blues, pop en country.
Gepubliceerd: 29 april 2026

Sleutelstad
Middelstegracht 87A
2312 TT Leiden
E-mail
redactie@sleutelstad.nl
Telefoon Redactie
071 - 5235907